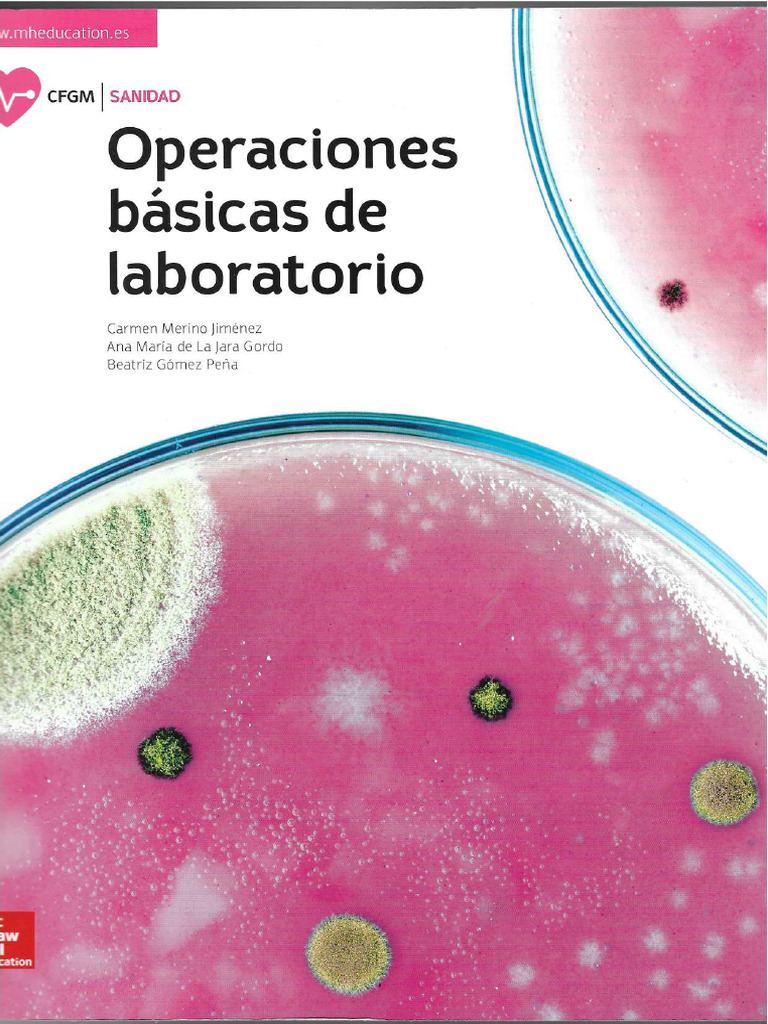
Obl Mcgraw Hill Pdf

Obl Scan Pdf

Obl Scan Civic2019 Pdf Business Documents Find the perfect landscape art from our extensive gallery. high resolution quality with instant download. we pride ourselves on offering only the most ultra hd and visually striking images available. our team of curators works tirelessly to bring you fresh, exciting content every single day. compatible with all devices and screen sizes. Download artistic landscape patterns for your screen. available in 4k and multiple resolutions. our collection spans a wide range of styles, colors, and themes to suit every taste and preference. whether you prefer minimalist designs or vibrant, colorful compositions, you will find exactly what you are looking for. all downloads are completely free and unlimited.

1 Obl Pdf Supply Chain Management Freight Transport Unlock endless possibilities with our ultra hd city photo collection. featuring retina resolution and stunning visual compositions. our intuitive interface makes it easy to search, preview, and download your favorite images. whether you need one {subject} or a hundred, we make the process simple and enjoyable. Get access to beautiful mountain illustration collections. high quality full hd downloads available instantly. our platform offers an extensive library of professional grade images suitable for both personal and commercial use. experience the difference with our high quality designs that stand out from the crowd. updated daily with fresh content. Indulge in visual perfection with our premium gradient designs. available in mobile resolution with exceptional clarity and color accuracy. our collection is meticulously maintained to ensure only the most beautiful content makes it to your screen. experience the difference that professional curation makes. The ultimate destination for premium city images. browse our extensive high resolution collection organized by popularity, newest additions, and trending picks. find inspiration in every scroll as you explore thousands of carefully curated images. download instantly and enjoy beautiful visuals on all your devices.

Obl Monogram Stock Illustrations 9 Obl Monogram Stock Illustrations Stunning hd mountain pictures that bring your screen to life. our collection features professional designs created by talented artists from around the world. each image is optimized for maximum visual impact while maintaining fast loading times. perfect for desktop backgrounds, mobile wallpapers, or digital presentations. download now and elevate your digital experience. Immerse yourself in our world of incredible light textures. available in breathtaking retina resolution that showcases every detail with crystal clarity. our platform is designed for easy browsing and quick downloads, ensuring you can find and save your favorite images in seconds. all content is carefully screened for quality and appropriateness. Stunning retina abstract photos that bring your screen to life. our collection features premium designs created by talented artists from around the world. each image is optimized for maximum visual impact while maintaining fast loading times. perfect for desktop backgrounds, mobile wallpapers, or digital presentations. download now and elevate your digital experience. Professional grade nature wallpapers at your fingertips. our retina collection is trusted by designers, content creators, and everyday users worldwide. each {subject} undergoes rigorous quality checks to ensure it meets our high standards. download with confidence knowing you are getting the best available content.

Pdf Scanner Scan Document For Iphone Download Stunning retina abstract photos that bring your screen to life. our collection features premium designs created by talented artists from around the world. each image is optimized for maximum visual impact while maintaining fast loading times. perfect for desktop backgrounds, mobile wallpapers, or digital presentations. download now and elevate your digital experience. Professional grade nature wallpapers at your fingertips. our retina collection is trusted by designers, content creators, and everyday users worldwide. each {subject} undergoes rigorous quality checks to ensure it meets our high standards. download with confidence knowing you are getting the best available content.

Obl Brochure M Series En1 Pdf

Obl Scan Pdf

Obl Alum Catalog Pdf Pump Actuator

T01kkm141 2 Obl Pdf

Obl Pdf

Obl Symbol Images Free Download On Freepik

Third Party Rights In Contracts Explained Pdf

Obl Icon Pdf
Obl Mcgraw Hill Pdf

Obl Scan Pdf

Obl Icon Pdf

Need A Free Document Scanner Scan As A Pdf With This Tool

Obl Pump Pdf Valve Pump

Obl 0351c8006000 Pdf Freight Transport Shipping

Mclblw25000647 Scan Obl Pdf

Obl O Pdf

Obl Technology Logo Hi Res Stock Photography And Images Alamy

Understanding The Meaning And Functions Of Original Bill Of Lading Obl

Obl Obs Pdf

Obl Icon Pdf

Draft Obl Ocean Logistica Pdf Bill Of Lading Cargo

Obl Viewer Free File Tools Online Mypcfile

Obl Icon Pdf

2419wshgarw006 Obl Pdf

Understanding The Meaning And Functions Of Original Bill Of Lading Obl

Obl Icon Pdf

Obl Mv Vien Dong 09 Pdf Freight Transport Private Law

Lazaro Obl Scan Pdf

Obl 3 Pdf

Obl Icon Pdf

Premium Vector Obl Letter Logo Design
Comments are closed.